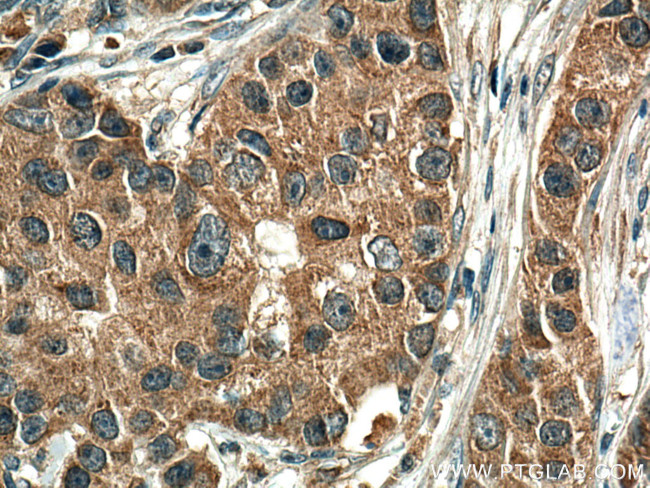
EIF2AK1 Antibody in Immunohistochemistry (Paraffin) (IHC (P))

Search
Proteintech
EIF2AK1 Monoclonal Antibody (2H1F3)
{{$productOrderCtrl.translations['antibody.pdp.commerceCard.promotion.promotions']}}
{{$productOrderCtrl.translations['antibody.pdp.commerceCard.promotion.viewpromo']}}
{{$productOrderCtrl.translations['antibody.pdp.commerceCard.promotion.promocode']}}: {{promo.promoCode}} {{promo.promoTitle}} {{promo.promoDescription}}. {{$productOrderCtrl.translations['antibody.pdp.commerceCard.promotion.learnmore']}}
产品信息
67674-1-IG
种属反应
宿主/亚型
分类
类型
克隆号
抗原
偶联物
形式
浓度
规格
纯化类型
保存液
内含物
保存条件
运输条件
产品详细信息
Aliquoting is unnecessary for -20°C storage.
靶标信息
EIF2AK1 (HRI) is one of 4 kinases that specifically phosphorylate Ser51 of translation initiation factor eIF2-alpha in response to various environmental stresses, leading to a decrease in protein sythesis. In the case of EIF2AK1, signaling is initiated by low levels of heme. The HRI gene is localized to 7p22 where its 3' end slightly overlaps the 3' end of the gene JTV1. The two genes are transcribed from opposite strands and kinase activity is induced by low levels of heme and inhibited by the presence of heme.
仅用于科研。不用于诊断过程。未经明确授权不得转售。
篇参考文献 (0)
生物信息学
蛋白别名: EIF-2a; EIF2a protein; Eukaryotic translation initiation factor 2-alpha kinase 1; HCR; he; heme regulated initiation factor 2 alpha kinase; heme sensitive initiation factor 2a kinase; Heme-controlled repressor; Heme-regulated eukaryotic initiation factor eIF-2-alpha kinase; Heme-regulated inhibitor; heme-regulated repressor; hemin-controlled repressor; Hemin-sensitive initiation factor 2-alpha kinase; hHRI; predicted protein of HQ1362; protein kinase; unnamed protein product
基因别名: EIF2AK1; HCR; hHRI; HRI; KIAA1369; LEMSPAD; PRO1362
UniProt ID: (Human) Q9BQI3
Entrez Gene ID: (Human) 27102